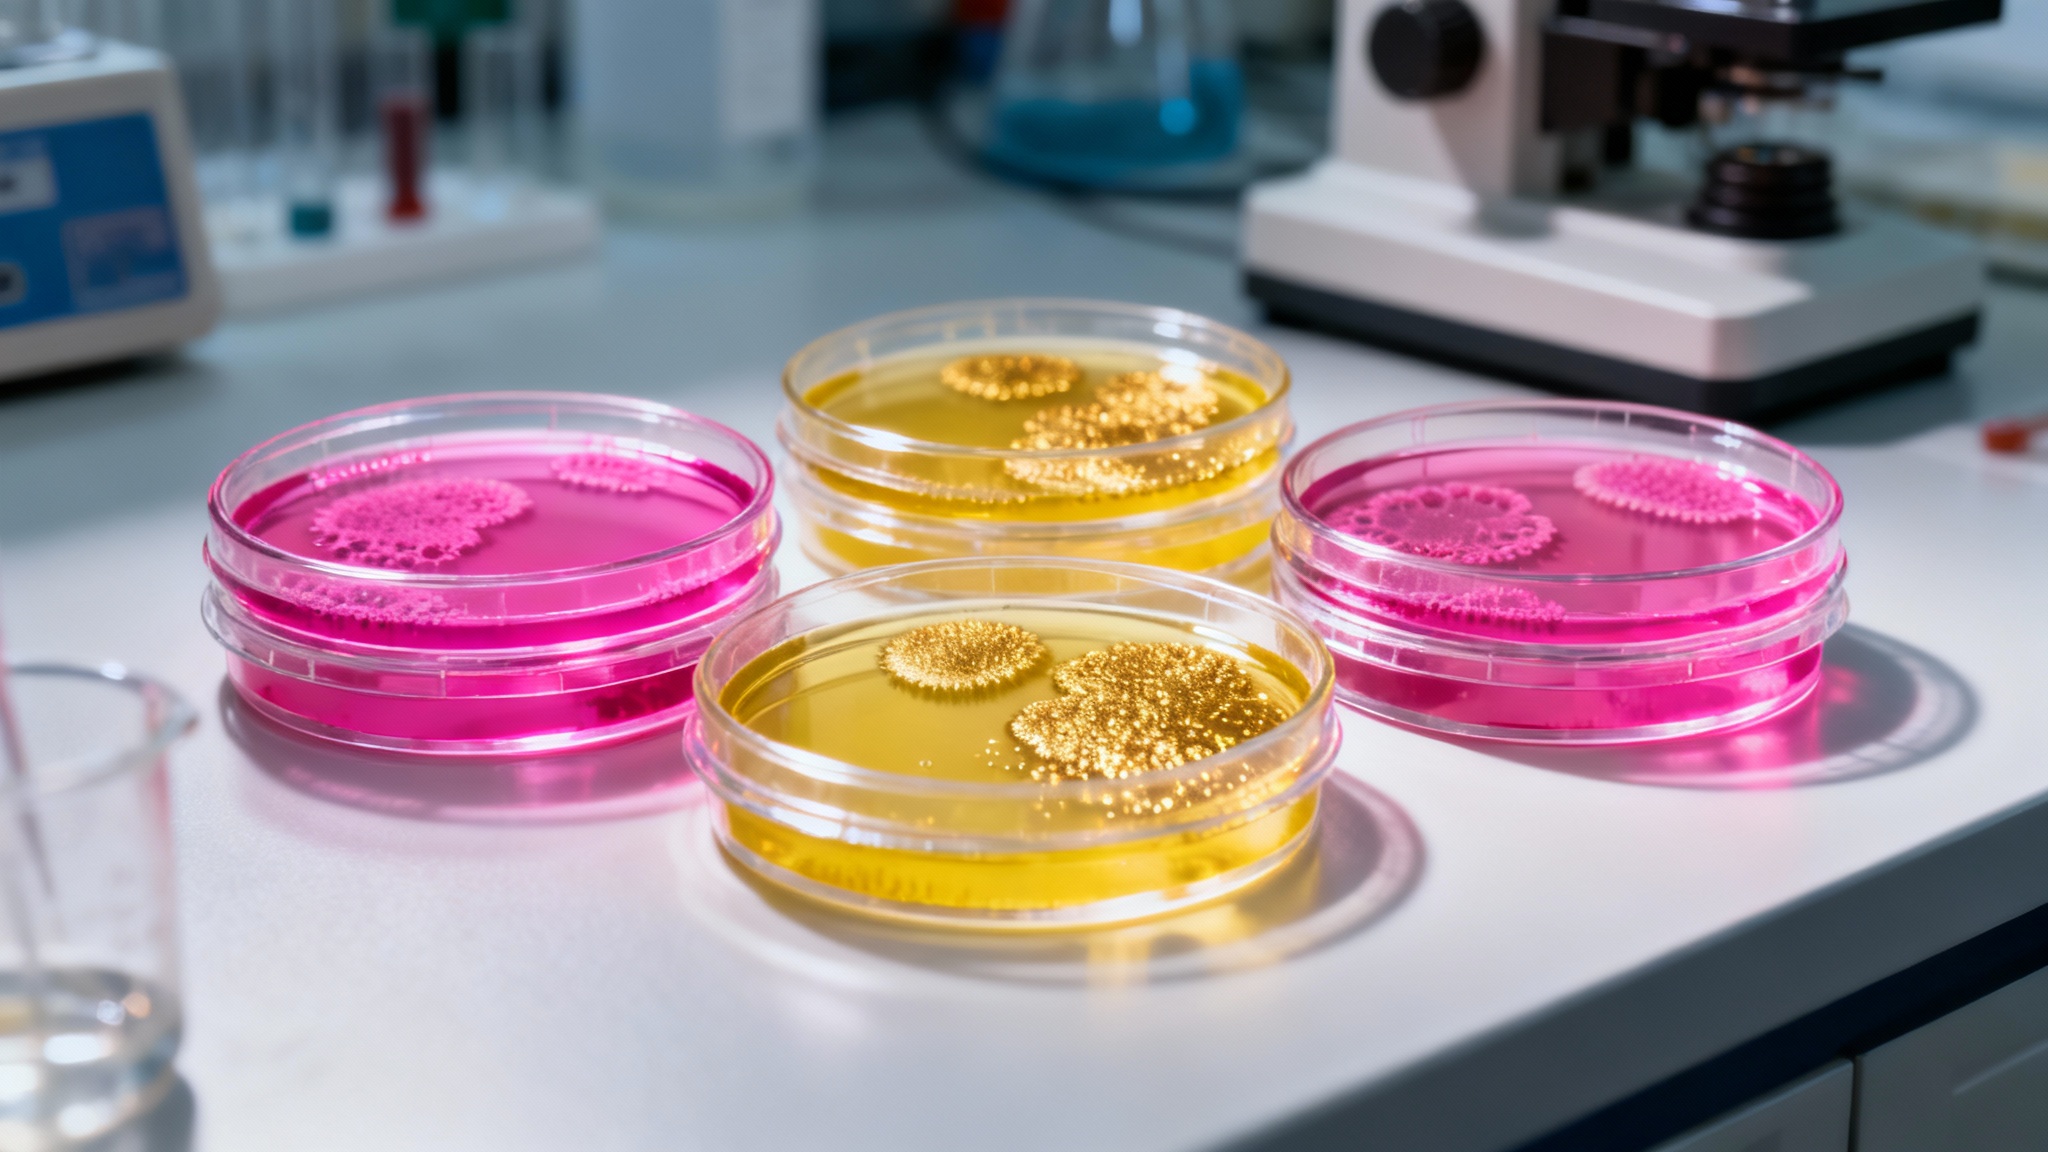
Une "bibliothèque de couleurs" pour la vie aérienne

Des couleurs dans les nuages : et si c’était le secret pour trouver la vie extraterrestre ?
Auteur: Mathieu Gagnon
Vous souvenez-vous de Carl Sagan ? Ce grand rêveur qui imaginait des créatures flottant dans les nuages de Jupiter. À l’époque, ça semblait être de la pure science-fiction. Et pourtant, aujourd’hui, des scientifiques viennent de faire un premier pas, un vrai, pour voir si son intuition était juste.
Une équipe de l’Institut Carl Sagan de l’Université Cornell a fait une découverte assez incroyable : des micro-organismes, de toutes petites formes de vie, qui vivent tout là-haut dans notre atmosphère, possèdent des couleurs. Ces couleurs ne sont pas là pour faire joli ; elles leur servent de bouclier contre la lumière du soleil. Et ce sont précisément ces pigments colorés qui pourraient nous aider, un jour, à repérer la vie sur d’autres planètes. C’est la première fois qu’on mesure comment ces microbes aériens renvoient la lumière, et les résultats sont… disons, pleins de promesses.
Un monde invisible au-dessus de nos têtes

On a tendance à penser que le ciel est vide, mais c’est tout le contraire. L’atmosphère est un véritable océan d’air, parcouru par la vie. Des cellules, des spores, des bactéries sont emportées par les vents depuis la terre et les mers. C’est fou, non ?
Les scientifiques ont compté jusqu’à des dizaines de milliers de cellules vivantes dans un seul mètre cube d’air. Certaines peuvent survivre des années là-haut, voyageant d’un continent à l’autre. Elles se nourrissent de gaz, comme l’hydrogène ou le méthane, et certaines arrivent même à puiser l’eau dont elles ont besoin directement dans l’air. D’autres se nichent dans les gouttelettes des nuages, profitant de la moindre humidité pour se développer. On l’oublie souvent, mais le ciel est un véritable écosystème. Pour la vie, un nuage peut être un foyer aussi accueillant que la terre ou l’océan.
La couleur, une armure pour survivre

En haute altitude, la lumière du soleil est si forte qu’elle peut détruire une cellule en quelques secondes. C’est là que les pigments entrent en jeu. Ils agissent comme une véritable armure. Le rouge, le jaune, l’orange… ces couleurs absorbent les rayons ultraviolets dangereux et les transforment en simple chaleur, sans danger.
Cette couleur, ce n’est donc pas de la coquetterie, c’est de la chimie de survie. Et le plus intéressant, c’est que lorsque la lumière frappe ces pigments, elle est réfléchie d’une manière bien particulière, une sorte de signature unique qui crie : « ici, il y a de la vie ! ». Chaque couleur a son propre « code-barres » lumineux. Des télescopes assez puissants pourraient un jour repérer ces signatures dans les nuages d’une planète lointaine.
Une "bibliothèque de couleurs" pour la vie aérienne
Pour savoir à quoi ressemblerait cette signature, l’équipe de recherche a cultivé en laboratoire sept types de bactéries. Celles-ci avaient été collectées dans la stratosphère, entre 20 et 30 kilomètres au-dessus de nos têtes. De vraies survivantes !
Ensuite, avec un appareil très précis, un spectromètre, ils ont mesuré comment chaque colonie de microbes réfléchissait la lumière. Ils ont même testé les échantillons frais, puis après une semaine de séchage, pour imiter ce qui se passe dans un nuage humide ou sec. Le résultat ? Chaque bactérie avait une signature lumineuse distincte, surtout dans les couleurs visibles. Celles qui étaient roses contenaient des pigments similaires à ce qu’on trouve dans les tomates, et les jaunes, des pigments qu’on retrouve dans les soucis. Ils ont ainsi créé la toute première « bibliothèque » de couleurs de la vie dans les airs.
Et si on simulait des ciels extraterrestres ?

Forts de ces résultats, les chercheurs sont allés plus loin. Ils ont utilisé un simulateur informatique pour voir comment ces couleurs apparaîtraient sur des planètes très différentes : des mondes recouverts d’océans, des planètes glacées, ou des cousines de la Terre.
Dès qu’ils ajoutaient ces pigments de vie dans l’atmosphère simulée, la lumière réfléchie par la planète changeait de manière visible. Les nuages humides devenaient un peu plus sombres, tandis que les nuages secs devenaient plus brillants. Cela veut dire que la simple luminosité des nuages d’une planète pourrait déjà nous donner des indices. Une teinte légèrement jaune ou rose dans la lumière d’une planète lointaine pourrait un jour être le premier signe que quelque chose de vivant flotte dans son ciel.
Conclusion : Lever les yeux, avec un nouvel espoir

Jusqu’à présent, pour chercher la vie ailleurs, on se concentrait surtout sur les gaz dans l’atmosphère, comme l’oxygène, ou sur la couleur verte des plantes à la surface. Ce nouveau travail ajoute une troisième piste passionnante : la vie en suspension dans l’air.
Même si la surface d’une planète est cachée par d’épais nuages, nous pourrions peut-être y déceler la vie. Cela élargit énormément le champ des recherches ! Bien sûr, il faudra des télescopes de nouvelle génération, incroyablement puissants, pour détecter ces faibles lueurs colorées. Mais l’idée est là, transformée en une véritable piste scientifique. La prochaine fois que vous regarderez les nuages, souvenez-vous qu’ils ne sont pas seulement faits d’eau. Ils sont une preuve que la vie n’a pas toujours besoin d’un sol pour s’épanouir. Parfois, un peu d’air lui suffit.
Selon la source : earth.com










